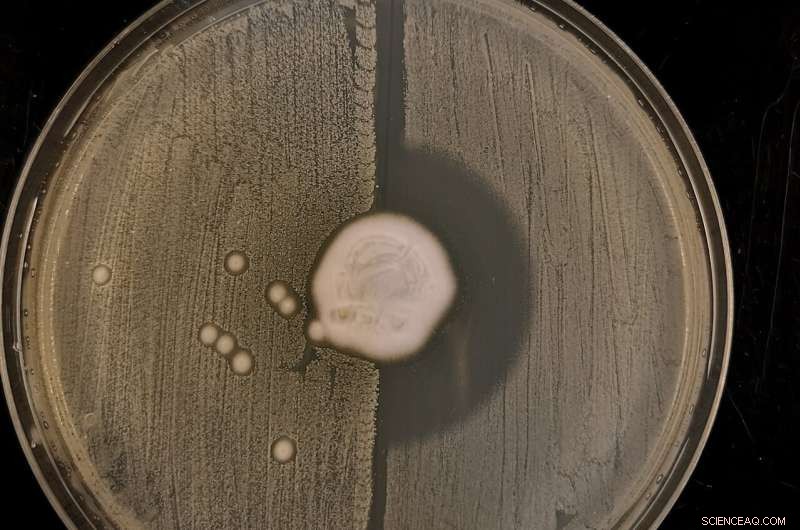
Ancient Origins of MRSA: New Research Reveals Resistance in Hedgehogs Before Antibiotics

Credit: CC0 Public Domain
Staphylococcus aureus first developed resistance to the antibiotic methicillin around 200 years ago, according to a large international collaboration including the University of Cambridge, the Wellcome Sanger Institute, Denmark's Serum Statens Institut and the Royal Botanic Gardens, Kew, which has traced the genetic history of the bacteria.
They were investigating the surprising discovery—from hedgehog surveys from Denmark and Sweden—that up to 60% of hedgehogs carry a type of MRSA called mecC-MRSA. The new study also found high levels of MRSA in swabs taken from hedgehogs across their range in Europe and New Zealand.
The study is published today in the journal Nature.
The researchers believe that antibiotic resistance evolved in Staphylococcus aureus as an adaptation to having to exist side-by-side on the skin of hedgehogs with the fungus Trichophyton erinacei, which produces its own antibiotics.
The resulting methicillin-resistant Staphylococcus aureus is better known as the superbug MRSA. The discovery of this centuries-old antibiotic resistance predates antibiotic use in medical and agricultural settings.
Photo shows fungus Trichophyton erinacei growing in the centre of an agar plate streaked with MRSA on the left half and methicillin-susceptible Staphylococcus aureus bacteria on the right. The fungus produces antibiotics, which kill methicillin-susceptible Staphylococcus aureus bacteria but not MRSA, resulting in a clear zone on the right with no bacterial growth. Credit: Claire L. Raisen
"Using sequencing technology we have traced the genes that give mecC-MRSA its antibiotic resistance all the way back to their first appearance, and found they were around in the nineteenth century," said Dr. Ewan Harrison, a researcher at the Wellcome Sanger Institute and University of Cambridge and a senior author of the study.
He added: "Our study suggests that it wasn't the use of penicillin that drove the initial emergence of MRSA, it was a natural biological process. We think MRSA evolved in a battle for survival on the skin of hedgehogs, and subsequently spread to livestock and humans through direct contact."
Antibiotic resistance in bugs causing human infections was previously thought to be a modern phenomenon, driven by the clinical use of antibiotics. Misuse of antibiotics is now accelerating the process, and antibiotic resistance is rising to dangerously high levels in all parts of the world.
Since almost all the antibiotics we use today arose in nature, the researchers say it is likely that resistance to them already exists in nature too. Overuse of any antibiotic in humans or livestock will favor resistant strains of the bug, so it is only a matter of time before the antibiotic starts to lose its effectiveness.
"This study is a stark warning that when we use antibiotics, we have to use them with care. There's a very big wildlife 'reservoir' where antibiotic-resistant bacteria can survive—and from there it's a short step for them to be picked up by livestock, and then to infect humans," said Professor Mark Holmes, a researcher in the University of Cambridge's Department of Veterinary Medicine and a senior author of the report.
In 2011, previous work led by Professor Holmes first identified mecC -MRSA in human and dairy cow populations. At the time it was assumed the strain had arisen in the cows because of the large amount of antibiotics they are routinely given.
MRSA was first identified in patients in 1960, and around 1 in 200 of all MRSA infections are caused by mecC-MRSA. Due to its resistance to antibiotics, MRSA is much harder to treat than other bacterial infections. The World Health Organization now considers MRSA one of the world's greatest threats to human health. It is also a major challenge in livestock farming.
The findings are not a reason to fear hedgehogs, say the researchers: humans rarely get infections with mecC-MRSA, even though it has been present in hedgehogs for more than 200 years.
"It isn't just hedgehogs that harbor antibiotic-resistant bacteria—all wildlife carries many different types of bacteria, as well as parasites, fungi and viruses," said Holmes.
He added: "Wild animals, livestock and humans are all interconnected: we all share one ecosystem. It isn't possible to understand the evolution of antibiotic resistance unless you look at the whole system."